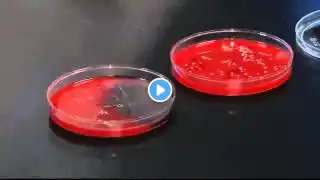
ภาพตัวอย่างวิดีโอ

SPECIAL REPORT: How dirty are your hands?
DAYTON -- The flu has wreaked havoc on much of the country, including right here in the Miami Valley.We've already had two flu related deaths.The main culprit could be the things you use everyday, your hands.During the winter months one of our biggest problems is bacteria and viruses and all types of diseases, which are improper or inadequate hand washing, said Bill Wharton, Director for the Dayton-Montgomery County Public Health Department.A lot of times when people go to the bathroom they walk over to the sink, they'll splash some water on their hands and grab a towel to dry it, that's accomplished absolutely nothing, said Wharton.We work with the public everyday and we shake hands with most people that come in and open the door for a greeting and we are very prone to getting a lot of diseases, said Jerry Van Hoss, employee at local car dealership.He's often forced to share his desk, phone and other office space with his co-workers.I try not to let not to let anybody use any of my stuff, he said.But it happens, so we wanted to find out what's on your co-workers hands.We had ten people swab their hands before they washed and then had them wash, and swab again.We then took those dishes to the lab, where they sat in an incubator for 24 hours.If you look on this plate here and you see the little green ones those are normal little mouth organisms, we call them mouth flora, said Ike Northern, Director of Infectious Disease and Teesting at Comunet Laboratories in Dayton.While those organisms might seem harmless, think again.If you see the things from your mouth, if someone has the flu or cold, those organisms are going to be on your hands too if you're seeing other mouth organisms, said Northern.That means if your co-worker has the flu from their mouth on their hands, and then touches your phone, desk, keyboard and mouse, by the end of the day the flu is everywhere, and it can live there for up to eight hours.But this can all be prevented.If people washed their hands and do it right, then we can prevent a tremendous amount of disease that goes around our community during the winter months, said Wharton, The proper way to wash your hands is to do it thoroughly and to do it for about 20 seconds.You don't actually have to count to 20-seconds, it's as easy as singing the ABC's or Happy Birthday to your self.You actually loosen the bateria and viruses when you use the soap and rubbing your hands together, and then when you rinse your hands your actually flushing everything that was on your hands off, said Wharton.The difference, is in the dishes.You'll notice that you have a lot of the organisms here, but when you wash your hands the only organisms left are the things that would be normally on your skin, said Northern.It's not always what's lurking in the bathroom that's dangerous to your health, it's what you bring in with you, that can bring it out.Do you take your phone into the bathroom with you? asked Elyse, It stays in my pocket usually, so yes, answered Samantha Gilliam, student at Sinclair Community College, I know my brother does, he'll be in the bathroom updating his facebook status.According to a new study, one in six cell phones had fecal matter on them.So we swabbed ten different phones to find out, and went back to the lab.See the little green one there, that's normal mouth organisms, said Northern.We found normal skin bacteria and again, bacteria from your mouth.Any time that you're culturing surfaces that people touch these are the types of organisms that you'll see, the normal things that live on your skin and the things that live in your mouth, said Northern.While local scientists say finding fecal matter on someone's phone isn't normal, it wouldn't be shocking.If people are going into the bathroom and using their phone while they're in the bathroom, you will find fecal material there so you could, that wouldn't surprise me if they found it on their phones, said Northern.So you think on his phone you might find some fecal matter or nasty stuff? asked Elyse, Yeah, some stuff I wouldn't want to think about, answered Gilliam.If you're worried about what you'll find, protecting yourself is easy.Just take an alcohol swab and clean the surface of your phone.But most importantly, wash your hands.Most people know it's important to wash their hands and don't do it, said Wharton.